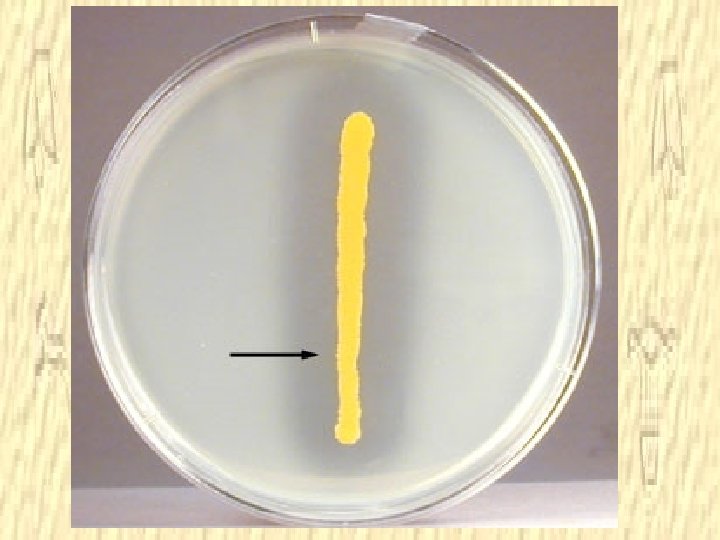
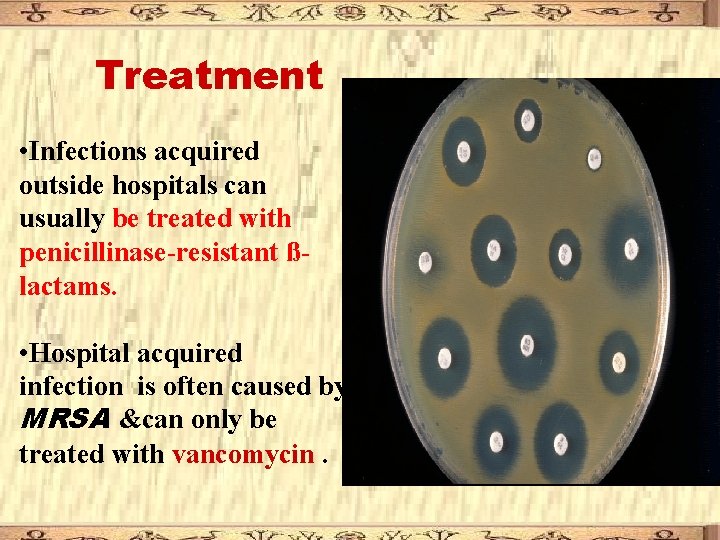
Treatment • Infections acquired outside hospitals can usually be treated with penicillinase-resistant ßlactams. • Treatment • Infections acquired outside hospitals can usually be treated with penicillinase-resistant ßlactams. •
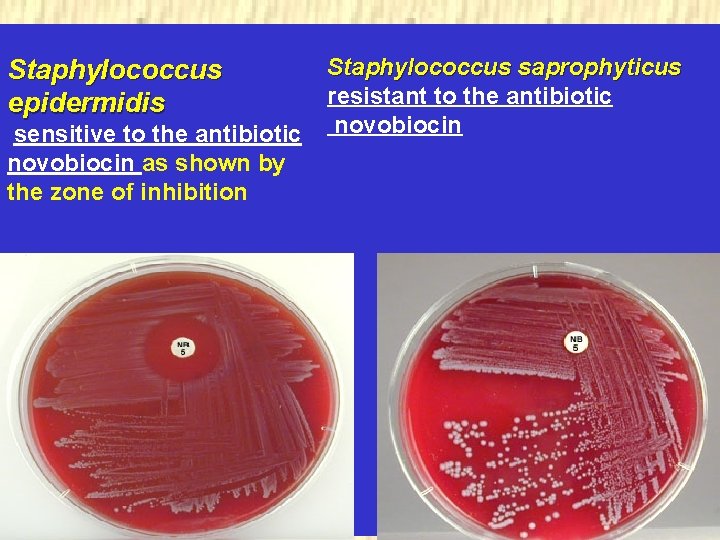
Staphylococcus epidermidis sensitive to the antibiotic novobiocin as shown by the zone of inhibition Staphylococcus epidermidis sensitive to the antibiotic novobiocin as shown by the zone of inhibition

The staphylococci Morphology Gram positive cocci arranged in

- Slides: 26
The staphylococci Morphology ØGram positive cocci Øarranged in clusters, Ønon spore forming Øand non motile. ØS. aureus form microcapsule, Øother species may produce slime layer.
Classification Coagulase positive: S. aureus Coagulase negative: S. epidermidis and S. saprophyticus
1 Staphylococcus aureus • Present as normal flora on skin & upper respiratory tract • 10 -40 % of normal individuals carry S. aureus in the anterior nares • It is a major pathogen for humans.
Enzymes and toxins produced by S. aureus: Enzymes: Coagulase and clumping factor: • Convert prothrombin to thrombin → conversion of fibrinogen to fibrin which coat the bacterial cell and interfere with opsonization and phagocytosis.
Enzymes: • Staphylokinase: causes lyses of fibrin. • Catalase: inactivates toxic hydrogen peroxide inside phagocytic cells and enhance survival of S. aureus in phagocytes. • Other enzymes: As proteases, lipase and deoxyribonuclease.
Staphylococcal exotoxins: 1) Membrane damaging toxins: as haemolysin and leukocidin. 2) Enterotoxins: 1 – 6 antigenic types (named A, B, C, D, E and G). – Cause food poisoning when ingested. – Heat and acid stable. 3)Toxic shock syndrome toxin (TSST-1): – Causes toxic shock syndrome. 4) Epidermolytic (exfoliative) toxin: • causes scalded skin syndrome in neonates.
Diseases caused by S. aureus A) Suppurative (pus-forming) infections: • Skin lesions: boils, styes and furunculosis. • Invasive infections: Pneumonia, meningitis, urinary tract infections, bacteremia, endocarditis, …etc. B) Toxigenic diseases: • Scalded skin syndrome • Food poisoning: • Toxic shock syndrome:
Scalded skin syndrome • in neonates which results in widespread blistering and loss of the epidermis due to production of epidermolytic (exfoliative) toxin.
• Food poisoning: – Type of food: diary milk products. – Incubation period: 1 -8 hours. Short – Clinical picture: nausea, vomiting and diarrhea, but no fever.
• Toxic shock syndrome: – E. g. , Tampon-associated TSS occurs in young females who use tampons. Clinically, there is fever, vomiting, diarrhea, desquamation of skin and hypotension.
Laboratory Diagnosis of S. aureus infections: Samples: Differ according to the site of infection (swabs, pus, sputum, C. S. F, blood, . . . ). Direct film: Stained with Gram stain for Characteristic morphology.
Culture – facultative anaerobes, optimum temperature: 37 C, normal atmospheric CO 2 – Can grow on ordinary media. – S. aureus produce golden yellow endopigments. – S. aureus causes -hemolysis on blood agar. – Selective media for S. aureus is mannitol salt agar, where S. aureus ferments mannitol and salt inhibits other normal flora.
Identification of colonies • Film stained by Gram stain
Identification of colonies Coagulase test • Biochemical reactions : 1 - Catalase test 2 - Coagulase test 3 - Mannitol fermentation Catalase test
Treatment • Infections acquired outside hospitals can usually be treated with penicillinase-resistant ßlactams. • Hospital acquired infection is often caused by MRSA &can only be treated with vancomycin.
Resistance of Staphylococci to Antimicrobial Drug • Hospital strains of S. aureus are resistant to different antibiotics. • A few strains are resistant to all clinically useful antibiotics except vancomycin, which may aid its survival in the hospital environment
The term MRSA refers to methicillin resistance Staphylococcus aureus Most methicillinresistant strains are also multiply resistant.
Coagulase Negative Staphylococci
S. epidermidis: Present as normal flora of the skin, non pathogenic, but may cause infections in immunocompromized individuals. S. saprophyticus: Causes urinary tract infection in young females.
Differences between staphylococcal species Test S. aureus S. epidermidis Coaguolase production + DNase production + Protein A on cell surface + Mannitol fermentation + Exotoxins production + Haemolysin novobiocin Resistance S. saprophyticus - - +
Staphylococcus epidermidis sensitive to the antibiotic novobiocin as shown by the zone of inhibition Staphylococcus saprophyticus. resistant to the antibiotic novobiocin